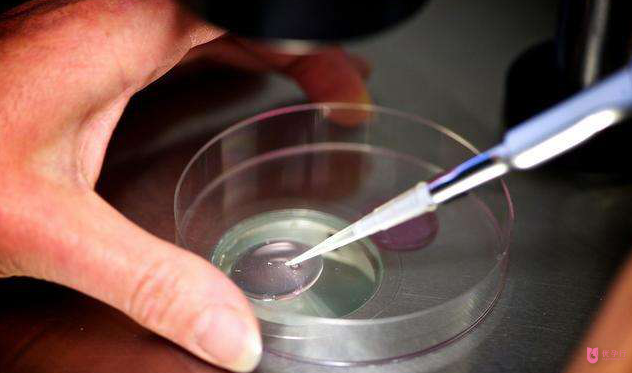
QQ圖片20180122164335.png

當(dāng)前位置:泰國試管嬰兒 > 試管嬰兒反復(fù)失敗?可能你需要先定一個鉆石培養(yǎng)皿
時間:2018-01-22
去年網(wǎng)上流傳著一張關(guān)于受精的詼諧圖片:如果你抱怨生活這么艱辛,那當(dāng)年的那場游泳比賽你就不該拿第一。
較近,來自德國烏爾姆大學(xué)(Ulm University in Germany)的一項研究或許會讓你更沒有理由喊累。

目前,體外受精在難孕癥治療中發(fā)揮著越來越重要的作用。體外受精獲得的孩子就是人們通俗上說的“試管嬰兒”。這項技術(shù)一直是不能通過自然方式受孕婦女的一個福音。但目前就我國而言,各大醫(yī)院試管嬰兒的成功幾率并不高,平均僅30%左右。
較近,德國烏爾姆大學(xué)的物理學(xué)家Andrei Sommer領(lǐng)導(dǎo)的一項研究發(fā)現(xiàn),人類精子細(xì)胞在鉆石包被(a diamond petri dish)的培養(yǎng)皿上存活的時間和運動活性,都高于在傳統(tǒng)的聚苯乙烯培養(yǎng)皿上,而且用近紅外光照射也能提高精子的活性,兩者單獨或者聯(lián)合使用能夠提高體外受精的成功幾率。這對難孕癥的治療具有重要的意義。
傳統(tǒng)的體外受精過程是分別將精子與卵母細(xì)胞取出,置于培養(yǎng)液內(nèi)使精子鉆入卵母細(xì)胞內(nèi)形成受精卵,然后再將該受精卵移植回母體的子宮內(nèi)。臨床上通常是在培養(yǎng)皿上完成體外受精的,而目前常用的培養(yǎng)皿幾乎都是以聚苯乙烯為原料生產(chǎn)的。
像任何類型的細(xì)胞一樣,精子在代謝過程中也會產(chǎn)生對細(xì)胞有損害作用的活性氧類(ROS)?;钚匝跤捎诤形磁鋵Φ碾娮?,因此化學(xué)性質(zhì)非?;钴S,會與細(xì)胞膜、細(xì)胞內(nèi)的蛋白質(zhì)、脂質(zhì)等相互作用,引起一系列交聯(lián)反應(yīng),對細(xì)胞甚至機體造成各種損傷。在體內(nèi),活性氧會與周圍的物質(zhì)相互作用,過程中會得到或失去一個電子而變成穩(wěn)定的結(jié)構(gòu),失去損傷細(xì)胞的能力。
聚苯乙烯材料會在其表面形成一道膠狀的納米厚度的水膜的性質(zhì),但這層水膜會阻礙活性氧與周圍物質(zhì)的相互作用,因此不利于活性氧的中和消除。
一般來說,樣品中精子的運動活性越高,體外受精成功幾率越高,懷孕率也越高。
由于鉆石的表面形成的是一層光滑的水膜,不會阻礙自由基與周圍物質(zhì)的相互作用,可以保護(hù)細(xì)胞免受自由基的傷害。因此Sommer和他的同事們好奇,將精子培養(yǎng)于像鉆石這類材料的表面,是否會提高體外受精的成功幾率呢?
于是研究人員用少于一個微米的超薄鉆石層包被石英培養(yǎng)皿,并將人的精子培養(yǎng)于其中,并在聚苯乙烯包被的培養(yǎng)皿上重復(fù)相同的實驗作為對照。這些精子細(xì)胞的活性被分成從A(快速運動,較可能受精)到D(完全不動,不能受精)四個等級。
放置一個小時后,他們發(fā)現(xiàn)鉆石包被的培養(yǎng)皿中A等級精子的數(shù)目是聚苯乙烯培養(yǎng)皿中A等級精子數(shù)目的300%。該項研究結(jié)果發(fā)表在了轉(zhuǎn)化醫(yī)學(xué)年報《Annalsof Translational Medicine》上了。Sommer解釋說,這可能是因為在鉆石包被的培養(yǎng)皿表面,活性氧類不能聚集,很快地就被轉(zhuǎn)變?yōu)橹行缘奈镔|(zhì),失去損害細(xì)胞的能力。
以前也有研究表明,特定波長的光,如波長670納米的光(在可見光譜的紅光末端),可以提高細(xì)胞內(nèi)線粒體產(chǎn)生ATP(三磷酸腺苷)的含量,這使細(xì)胞更加具有活力。于是,該團(tuán)隊又測試了光照對精子活性的影響。經(jīng)過三十分鐘該波段光的照射下,研究人員發(fā)現(xiàn),實驗組A級精子的數(shù)目是對照組的兩倍。
這些研究結(jié)果表明,鉆石包被的培養(yǎng)皿和近紅外光照射的聯(lián)合使用,將會使精子存活時間更長,運動活性更高,進(jìn)而顯著提高體外受精的效率。

當(dāng)然,鉆石包被的培養(yǎng)皿的價格比較昂貴,像研究中用到的培養(yǎng)皿的價錢大概在100美元左右。但Sommer表示,考慮到體外受精大概要花費10,000美元甚至更多的時候,這個培養(yǎng)皿的價錢還是可以接受的。
美國俄亥俄州克利夫蘭診所生殖醫(yī)學(xué)中心的生物學(xué)家Ashok Agarwal說,這項研究不僅有趣,而且對生殖生物學(xué)的發(fā)展有重要的意義。
但是有一些研究人員擔(dān)心鉆石會對精子和受精卵造成損傷。Sommer也回應(yīng)說,研究中確實會涉及到納米鉆石顆粒進(jìn)入精子細(xì)胞的現(xiàn)象,但如果精子細(xì)胞位于惰性鉆石粒子表面則不會發(fā)生這種情況。盡管如此,該研究結(jié)果離臨床應(yīng)用還有很長的路要走。
也許未來,獲得一個健康的試管嬰兒是從先訂購一個鉆石包被的培養(yǎng)皿開始的。
對于鉆石培養(yǎng)皿可能是一個傳說,未來是否可行還有點研究,對于試管嬰兒反復(fù)失敗的家庭,又應(yīng)該如何選擇呢?
要不要做三代試管嬰兒PGS胚胎植入前染色體篩查?
一般人群中有1/5―1/4患有遺傳性疾病,平均每人攜帶5―6個隱性基因。但是不是所有問題都會影響孩子的健康,也不是所有問題都能夠被PGS/PGD技術(shù)檢出!
一、染色體問題有多嚴(yán)重?
首先要說明的是,能夠順利出生的健康嬰兒其實只是冰山一角,大多數(shù)有染色體異常的胚胎都會不著床、流產(chǎn)、或者胎停育,被自然淘汰。99%的流產(chǎn)是胎兒的原因,而不是母體的原因。
統(tǒng)計數(shù)據(jù)表明:
· 在受精卵階段,染色體異常比例為45%
· 成功著床的胚胎,染色體異常比例為25%
· 度過第一妊娠期的胚胎,染色體異常比例為15%
如果夫婦雙方?jīng)]有已確診的染色體問題,一般患者都建議采用標(biāo)準(zhǔn)方案即可。如果夫婦雙方有明確的遺傳病史,或曾經(jīng)流產(chǎn)或生育過有染色體問題的孩子,請?zhí)峁z測報告,我們會為您建議合適案。
四、胚胎采樣技術(shù)降低風(fēng)險
第三代試管嬰兒培養(yǎng):
1)在第三天初期胚上打孔:從培養(yǎng)箱中取出胚胎,在專用顯微操作臺上用特定裝置將胚胎固定 ,然后用激光切除法在胚胎透明帶的合適位置上開一小孔,切除透明帶時避免損傷到內(nèi)部細(xì)胞。
2)胚胎繼續(xù)培養(yǎng)到第五天,形成囊胚:胚胎不斷分裂成長時,有部分細(xì)胞從開的小孔中滲出,從滲出細(xì)胞中吸取一個細(xì)胞進(jìn)入微細(xì)導(dǎo)管中。
3)將取出的細(xì)胞送檢:通過染色體提取和分析,判斷該胚胎有無遺傳疾病和鑒定胚胎,通常檢測結(jié)果需要2-4周。
4)將囊胚冷凍存儲:所有囊胚都將被冷凍存儲,等到染色體結(jié)果出來后,患者可以選擇胚胎進(jìn)行移植。
临沧市|
正安县|
新巴尔虎左旗|
孝昌县|
梨树县|
玛多县|
双江|
青河县|
宁远县|
德格县|
乌兰浩特市|
海丰县|
海伦市|
大连市|
龙岩市|
武威市|
兴安盟|
洛宁县|
杭州市|
闻喜县|
开原市|
海口市|
北票市|
榆林市|
山丹县|
尉犁县|
永福县|
新民市|
宜宾县|
汾阳市|
灵丘县|
恩平市|
敦煌市|
河北省|
利津县|
榕江县|
云龙县|
屯昌县|
仙桃市|
眉山市|
濮阳县|